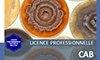

Niveau d'études visé
BAC +3
Composante
UFR Sciences et Techniques
Présentation
Accessibilité personnes en situation de handicap
Si vous rencontrez des difficultés liées à une maladie, à un handicap permanent ou passager, l’Espace Handicap, en collaboration avec le Service de santé étudiante et l’association partenaire Handisup, vous aide à préparer votre rentrée et l’aménagement de vos études et vous accompagne tout au long de votre cursus.
Organisation
Modalités pédagogiques
Les modalités pédagogiques sont adaptées en fonction des compétences et connaissances visées par l’enseignement. Sont notamment mobilisés les cours magistraux (CM), les travaux dirigés (TD) et/ou les travaux pratiques (TP).
Contrôle des connaissances
Selon les objectifs de la formation, le contrôle des connaissances et des compétences peut mobiliser différentes modalités d’évaluation tels le contrôle terminal, le contrôle continu, ou une combinaison de contrôle terminal et de contrôle continu. Ces évaluations peuvent prendre des formes variées (écrits et ou oral, travail de groupe, rapport/mémoires, etc.)
Ouvert en alternance
Cet enseignement est ouvert en alternance.
Programme
Sélectionnez un programme
Licence Professionnelle Contrôles Agro-alimentaires et Biotechnologies
UE1 Analyses microbiologiques et moléculaires
8 créditsUE2 Biochimie, chimie, chimie de l'environnement
8 créditsUE3 Biotechnologies Végétales et Analyses Microscopiques
6 créditsUE4 Communication
4 créditsUE5 Connaissance de l'entreprise et insertion pro.
5 créditsUE6 Normes et Qualité
9 créditsUE7 Projet tutoré
9 créditsProjet tutoré
9 crédits
UE8 Stage en entreprise
11 créditsStage
11 crédits